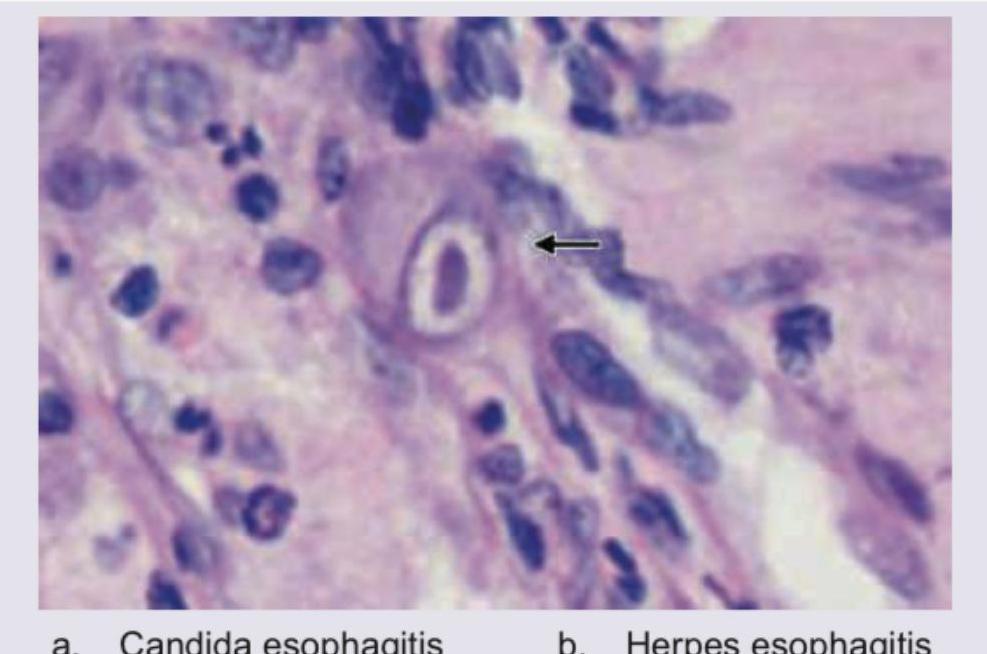
Image for question 1234

Amongst the four choices, select the virus whose life cycle is shown. (AIIMS Nov 2017)

Which of the following parasite is shown below?

Which of the following is responsible for the abnormality shown below?

A 40-year-old immunocompromised patient presents with complaints of dysphagia. UGI endoscopy shows multiple ulcers in distal esophagus. Biopsy was performed and histopathology is shown below. Diagnosis is:
Monkeypox, a viral zoonotic disease, is caused by
Consider the following statements regarding dengue virus : 1. It has four distinct serotypes. 2. Infection with any one serotype confers lifelong immunity for that virus serotype. 3. Secondary infection with dengue serotype 2 leads to severe form of dengue. Which of the statements given above are correct?
Which one of the following is a characteristic of Human Immunodeficiency Virus (HIV)?
Which one of the following is the correct sequence of appearance for the Hepatitis B virus serological markers?
Consider the following hepatitis viruses : 1. Hepatitis A 2. Hepatitis B 3. Hepatitis C 4. Hepatitis E Which of the above can be commonly transmitted through the faeco-oral route?
Which is the most specific causative agent of Rabies?
Explanation: ***Hepatitis B*** - The image clearly depicts the formation of **cccDNA (covalently closed circular DNA)** in the host cell nucleus, a unique and defining characteristic of the Hepatitis B virus life cycle. - The process of **reverse transcription** (synthesis of DNA from an RNA template) occurring within the core particle in the cytoplasm, followed by its movement to the nucleus to form cccDNA, is specific to Hepatitis B. *Herpes simplex* - Herpes simplex viruses are **DNA viruses** that replicate entirely within the nucleus, and their replication does not involve an RNA intermediate or the formation of cccDNA. - They also undergo **budding from the inner nuclear membrane** into the perinuclear space, which differs from the ER budding shown. *HIV* - HIV is a **retrovirus** that utilizes reverse transcriptase to convert its RNA genome into DNA, which then integrates into the host genome. However, it does not form cccDNA. - While it does involve reverse transcription, the overall replication strategy, particularly the integration step and the budding from the cell membrane, differs significantly from the depicted process. *Influenza* - Influenza is an **RNA virus** that replicates in the nucleus (unlike most RNA viruses) but does not involve a DNA intermediate or cccDNA formation. - Its replication cycle involves transcription of viral RNA into mRNA and replication of viral RNA genomes, which is distinct from the complex DNA to RNA to DNA cycle shown.
Explanation: ***Echinococcus granulosus*** - The image displays a **hydatid cyst**, characterized by its thick, laminated outer wall (ectocyst) and an inner germinal layer (endocyst) from which **brood capsules** and **protoscolices** (seen as invaginations) bud off. - This morphology is pathognomonic for **Echinococcus granulosus**, the causative agent of **cystic echinococcosis** (hydatid disease). *Cysticercosis cellulosae* - Cysts of *Cysticercus cellulosae* (larval stage of *Taenia solium*) typically appear as a fluid-filled bladder with a single **invaginated scolex** lacking the complex brood capsule arrangement seen in the image. - They also generally have a thinner cyst wall compared to *Echinococcus* cysts. *E. Histolytica* - *Entamoeba histolytica* is a **protozoan parasite** that causes amoebiasis, presenting as trophozoites or cysts; it does not form macroscopic cysts with complex internal structures like the one shown. - Amoebic abscesses are typically necrotic lesions, not true cysts with parasitic structures within. *Fasciola hepatica* - *Fasciola hepatica* is a **trematode (fluke)**, and its larval stages or adult worms do not form cysts with this characteristic morphology. - Liver flukes would appear as tissue sections of the flatworm itself in infected organs, not as a large, spherical cyst with internal budding structures.
Explanation: ***Zika virus*** - The image depicts a newborn with **microcephaly**, characterized by a significantly smaller head circumference than expected, which is a hallmark congenital abnormality associated with **Zika virus infection** during pregnancy. - Zika virus is a **teratogen** that primarily targets neural progenitor cells, leading to severe brain malformations and microcephaly in developing fetuses. *Human parvovirus B19* - This virus is known to cause **erythema infectiosum** (fifth disease) in children and can lead to **hydrops fetalis**, severe anemia, and cardiac failure in fetuses if transmitted during pregnancy. - It does not typically cause microcephaly as its primary congenital manifestation. *HHV6* - Human Herpesvirus 6 (HHV6) is the causative agent of **roseola infantum** (exanthem subitum) in young children. - While it can cause febrile seizures and encephalitis, it is not primarily associated with congenital microcephaly or other severe birth defects when acquired prenatally. *EBV* - Epstein-Barr virus (EBV) is responsible for **infectious mononucleosis** and is linked to various malignancies. - Congenital EBV infection is rare and has been associated with a range of non-specific outcomes, but it is not a recognized cause of microcephaly.
Explanation: ***CMV esophagitis*** - The image shows a classic "owl's eye" inclusion, which is a characteristic cytopathic effect of **Cytomegalovirus (CMV)** infection. - CMV esophagitis typically causes large, linear ulcers in the distal esophagus of **immunocompromised patients**, matching the patient's presentation. *Candida esophagitis* - This condition presents with white plaques and fuzzy exudates on endoscopy, and biopsy reveals **yeast and pseudohyphae**, which are not seen in the image. - While it occurs in immunocompromised patients, the microscopic findings are distinct from those of CMV. *Herpes esophagitis* - Herpes esophagitis is characterized by multiple, small, punched-out ulcers and microscopic findings of **Cowdry A inclusions** and **multinucleated giant cells**. - The "owl's eye" inclusion seen in the image is not typical for herpes simplex virus infection. *Barrett's esophagus* - Barrett's esophagus is a metaplastic change in the esophageal lining where **squamous epithelium** is replaced by **columnar epithelium with goblet cells**, usually due to chronic GERD. - It does not involve viral inclusions or ulcerations in the manner described in the clinical vignette or depicted in the image.
Explanation: ***a double-stranded DNA virus*** - Monkeypox is caused by the **monkeypox virus (MPXV)**, which belongs to the **Poxviridae family**. - Viruses in the Poxviridae family are known for having a **double-stranded DNA genome**. *a single-stranded RNA virus* - Many common viruses, such as **SARS-CoV-2 (COVID-19)**, **influenza virus**, and **HIV**, are single-stranded RNA viruses. - This genomic structure is fundamentally different from that of the monkeypox virus. *a single-stranded DNA virus* - Viruses like **Parvovirus B19** are single-stranded DNA viruses. - This type of genome is less common in human pathogens compared to double-stranded DNA or RNA viruses. *a double-stranded RNA virus* - Viruses such as **rotaviruses**, which cause gastroenteritis, are double-stranded RNA viruses. - While also double-stranded, its RNA nature distinguishes it from the DNA genome of monkeypox virus.
Explanation: ***1 and 2 only*** - Dengue virus indeed has **four distinct serotypes (DENV-1, DENV-2, DENV-3, DENV-4)**, explaining different epidemiological patterns and reinfections. - Infection with one serotype provides **lifelong homologous immunity** against that specific serotype, meaning a person will not get sick again from the same serotype. *2 and 3 only* - While statement 2 is correct, statement 3 is not universally true, as severe dengue can occur with secondary infection of any serotype, although **DENV-2** and **DENV-3** are more frequently implicated. - This option incorrectly excludes the fact that dengue has four distinct serotypes, which is a fundamental aspect of its biology and epidemiology. *1 and 3 only* - While statement 1 is correct, statement 3 is a simplification; severe dengue in secondary infections is due to **antibody-dependent enhancement (ADE)**, which can happen with various heterologous serotypes, not exclusively DENV-2. - This option incorrectly implies that infection with one serotype does not confer lifelong immunity to that specific serotype, which is a key characteristic of dengue immunity. *1, 2 and 3* - This option is incorrect because statement 3, while partially true, is too absolute. Severe dengue can be linked to **DENV-2** or **DENV-3** in secondary infections but isn't exclusive to DENV-2. - The risk of severe dengue is due to a **secondary infection** with a **heterologous serotype**, not specifically serotype 2, though DENV-2 often causes more severe illness in secondary infections.
Explanation: ***It is easily killed by heat*** - HIV is an **enveloped RNA virus** that is highly susceptible to inactivation by heat, typically at **56-60°C for 30 minutes**. - This characteristic is important for **sterilization of medical equipment** and understanding the environmental stability of the virus. - Heat lability is a key feature of enveloped viruses due to disruption of the lipid envelope. *It is easily killed by T4 lymphocytes* - **CD4+ T lymphocytes (T4 cells)** are the primary **target cells** for HIV, meaning the virus infects and ultimately destroys them. - HIV evades the immune system and **replicates within** these cells, leading to progressive immunodeficiency. - The virus is NOT killed by T4 cells; rather, it uses them for replication and destroys them in the process. *It cannot cross blood brain barrier* - HIV is known to **cross the blood-brain barrier (BBB)** early in infection, leading to neurological complications. - Presence of HIV in the central nervous system contributes to conditions like **HIV-associated neurocognitive disorder (HAND)** and HIV encephalopathy. - Infected macrophages and monocytes serve as "Trojan horses" carrying the virus across the BBB. *It is resistant to acetone* - HIV is an **enveloped virus**, and its lipid envelope is **susceptible to dissolution by lipid solvents** such as acetone, alcohol, and detergents. - This property makes HIV vulnerable to inactivation by common disinfectants and explains its poor environmental stability. - The envelope is essential for viral entry, so its disruption renders the virus non-infectious.
Explanation: ***HBsAg, HBeAg, Anti-HBc, Anti-HBe*** - **HBsAg** (Hepatitis B surface antigen) is the first marker to appear in acute infection, indicating active viral replication. - **HBeAg** (Hepatitis B e-antigen) appears shortly after HBsAg, correlating with high viral replication and infectivity. **Anti-HBc** (antibody to hepatitis B core antigen) is the next to appear, often during the window period. **Anti-HBe** (antibody to hepatitis B e-antigen) signals reduced viral replication and decreased infectivity, typically following the disappearance of HBeAg. *Anti-HBe, HBsAg, Anti-HBc* - This sequence is incorrect because **Anti-HBe** appears much later in the infection, typically after clearance of HBeAg, indicating reduced viral replication. - **HBsAg** is the earliest indicator of active infection, not appearing after Anti-HBe. *HBeAg, Anti-HBe, Anti-HBc, HBsAg* - This sequence is incorrect as **HBeAg** and **Anti-HBe** do not typically appear before **HBsAg**, which is the initial marker of viral presence. - The appearance of **Anti-HBe** before **HBsAg** is also not consistent with the natural history of Hepatitis B infection. *Anti-HBc, HBsAg, Anti-HBe* - This sequence is incorrect because **Anti-HBc** usually appears earlier than Anti-HBe, and while it can be detected relatively early, **HBsAg** is the first antigen to be detectable. - The appearance of **Anti-HBe** is a sign of decreasing viral activity and generally appears later than both HBsAg and Anti-HBc.
Explanation: ***Correct Answer: 1 and 4*** * Hepatitis A virus (**HAV**) and Hepatitis E virus (**HEV**) are primarily transmitted via the **faecal-oral route**, typically through contaminated food or water. * These infections are often acute and self-limiting, causing symptoms like jaundice, fatigue, and nausea. * HAV is more common in areas with poor sanitation, while HEV often causes waterborne outbreaks, particularly in developing countries. *Incorrect: 1 and 3 only* * While **Hepatitis A** is transmitted faecal-orally, **Hepatitis C** is primarily transmitted through blood-to-blood contact, such as sharing needles or contaminated blood transfusions. * Hepatitis C rarely, if ever, spreads via the faecal-oral route. *Incorrect: 2, 3 and 4* * **Hepatitis B** and **Hepatitis C** are transmitted through parenteral routes (e.g., blood, sexual contact, perinatal transmission), not via the faecal-oral route. * Although Hepatitis E is faecal-orally transmitted, including B and C makes this option incorrect. *Incorrect: 1, 2 and 3* * **Hepatitis A** is transmitted faecal-orally, but **Hepatitis B** and **Hepatitis C** are primarily transmitted through blood and body fluids (parenteral route). * This option incorrectly includes Hepatitis B and C in the faecal-oral transmission category.
Explanation: ***Rabies lyssavirus (RABV)*** - **Rabies lyssavirus (RABV)**, also known as the **classical rabies virus** or **genotype 1**, is the primary and most specific causative agent of rabies in humans and animals worldwide. - While other lyssaviruses (Lagos bat, Mokola, Duvenhage, Australian bat lyssavirus, etc.) can cause rabies-like illnesses, **RABV is overwhelmingly responsible** for the vast majority of documented rabies cases globally. - It is transmitted primarily through dog bites in endemic regions and causes acute, progressive, fatal encephalomyelitis. *Lagos bat lyssavirus (LBV)* - **Lagos bat lyssavirus (genotype 2)** is a distinct species within the *Lyssavirus* genus that can cause rabies-like disease, primarily in bats in Africa. - It is **rarely associated with human rabies** and is not the most common or specific cause globally. *Mokola lyssavirus (MOKV)* - **Mokola lyssavirus (genotype 3)** is another lyssavirus found in Africa, isolated from shrews, rodents, and rarely humans. - Although it can cause a fatal encephalomyelitis similar to rabies, human cases are **extremely rare**, and it is not considered the typical rabies virus. *Duvenhage lyssavirus (DUVV)* - **Duvenhage lyssavirus (genotype 4)** is a bat-associated lyssavirus found in Africa, first isolated in 1970. - Human cases are **exceptionally rare** (only a few documented cases), and it is not the primary causative agent of classic rabies.
Virus Structure and Classification
Practice Questions
Viral Replication
Practice Questions
Pathogenesis of Viral Infections
Practice Questions
DNA Viruses: Herpesviruses
Practice Questions
DNA Viruses: Poxviruses and Adenoviruses
Practice Questions
Hepatitis Viruses
Practice Questions
RNA Viruses: Orthomyxoviruses
Practice Questions
RNA Viruses: Paramyxoviruses
Practice Questions
Enteroviruses and Rhinoviruses
Practice Questions
Arboviruses
Practice Questions
HIV and Retroviruses
Practice Questions
Oncogenic Viruses
Practice Questions
Get full access to all questions, explanations, and performance tracking.
Start For Free